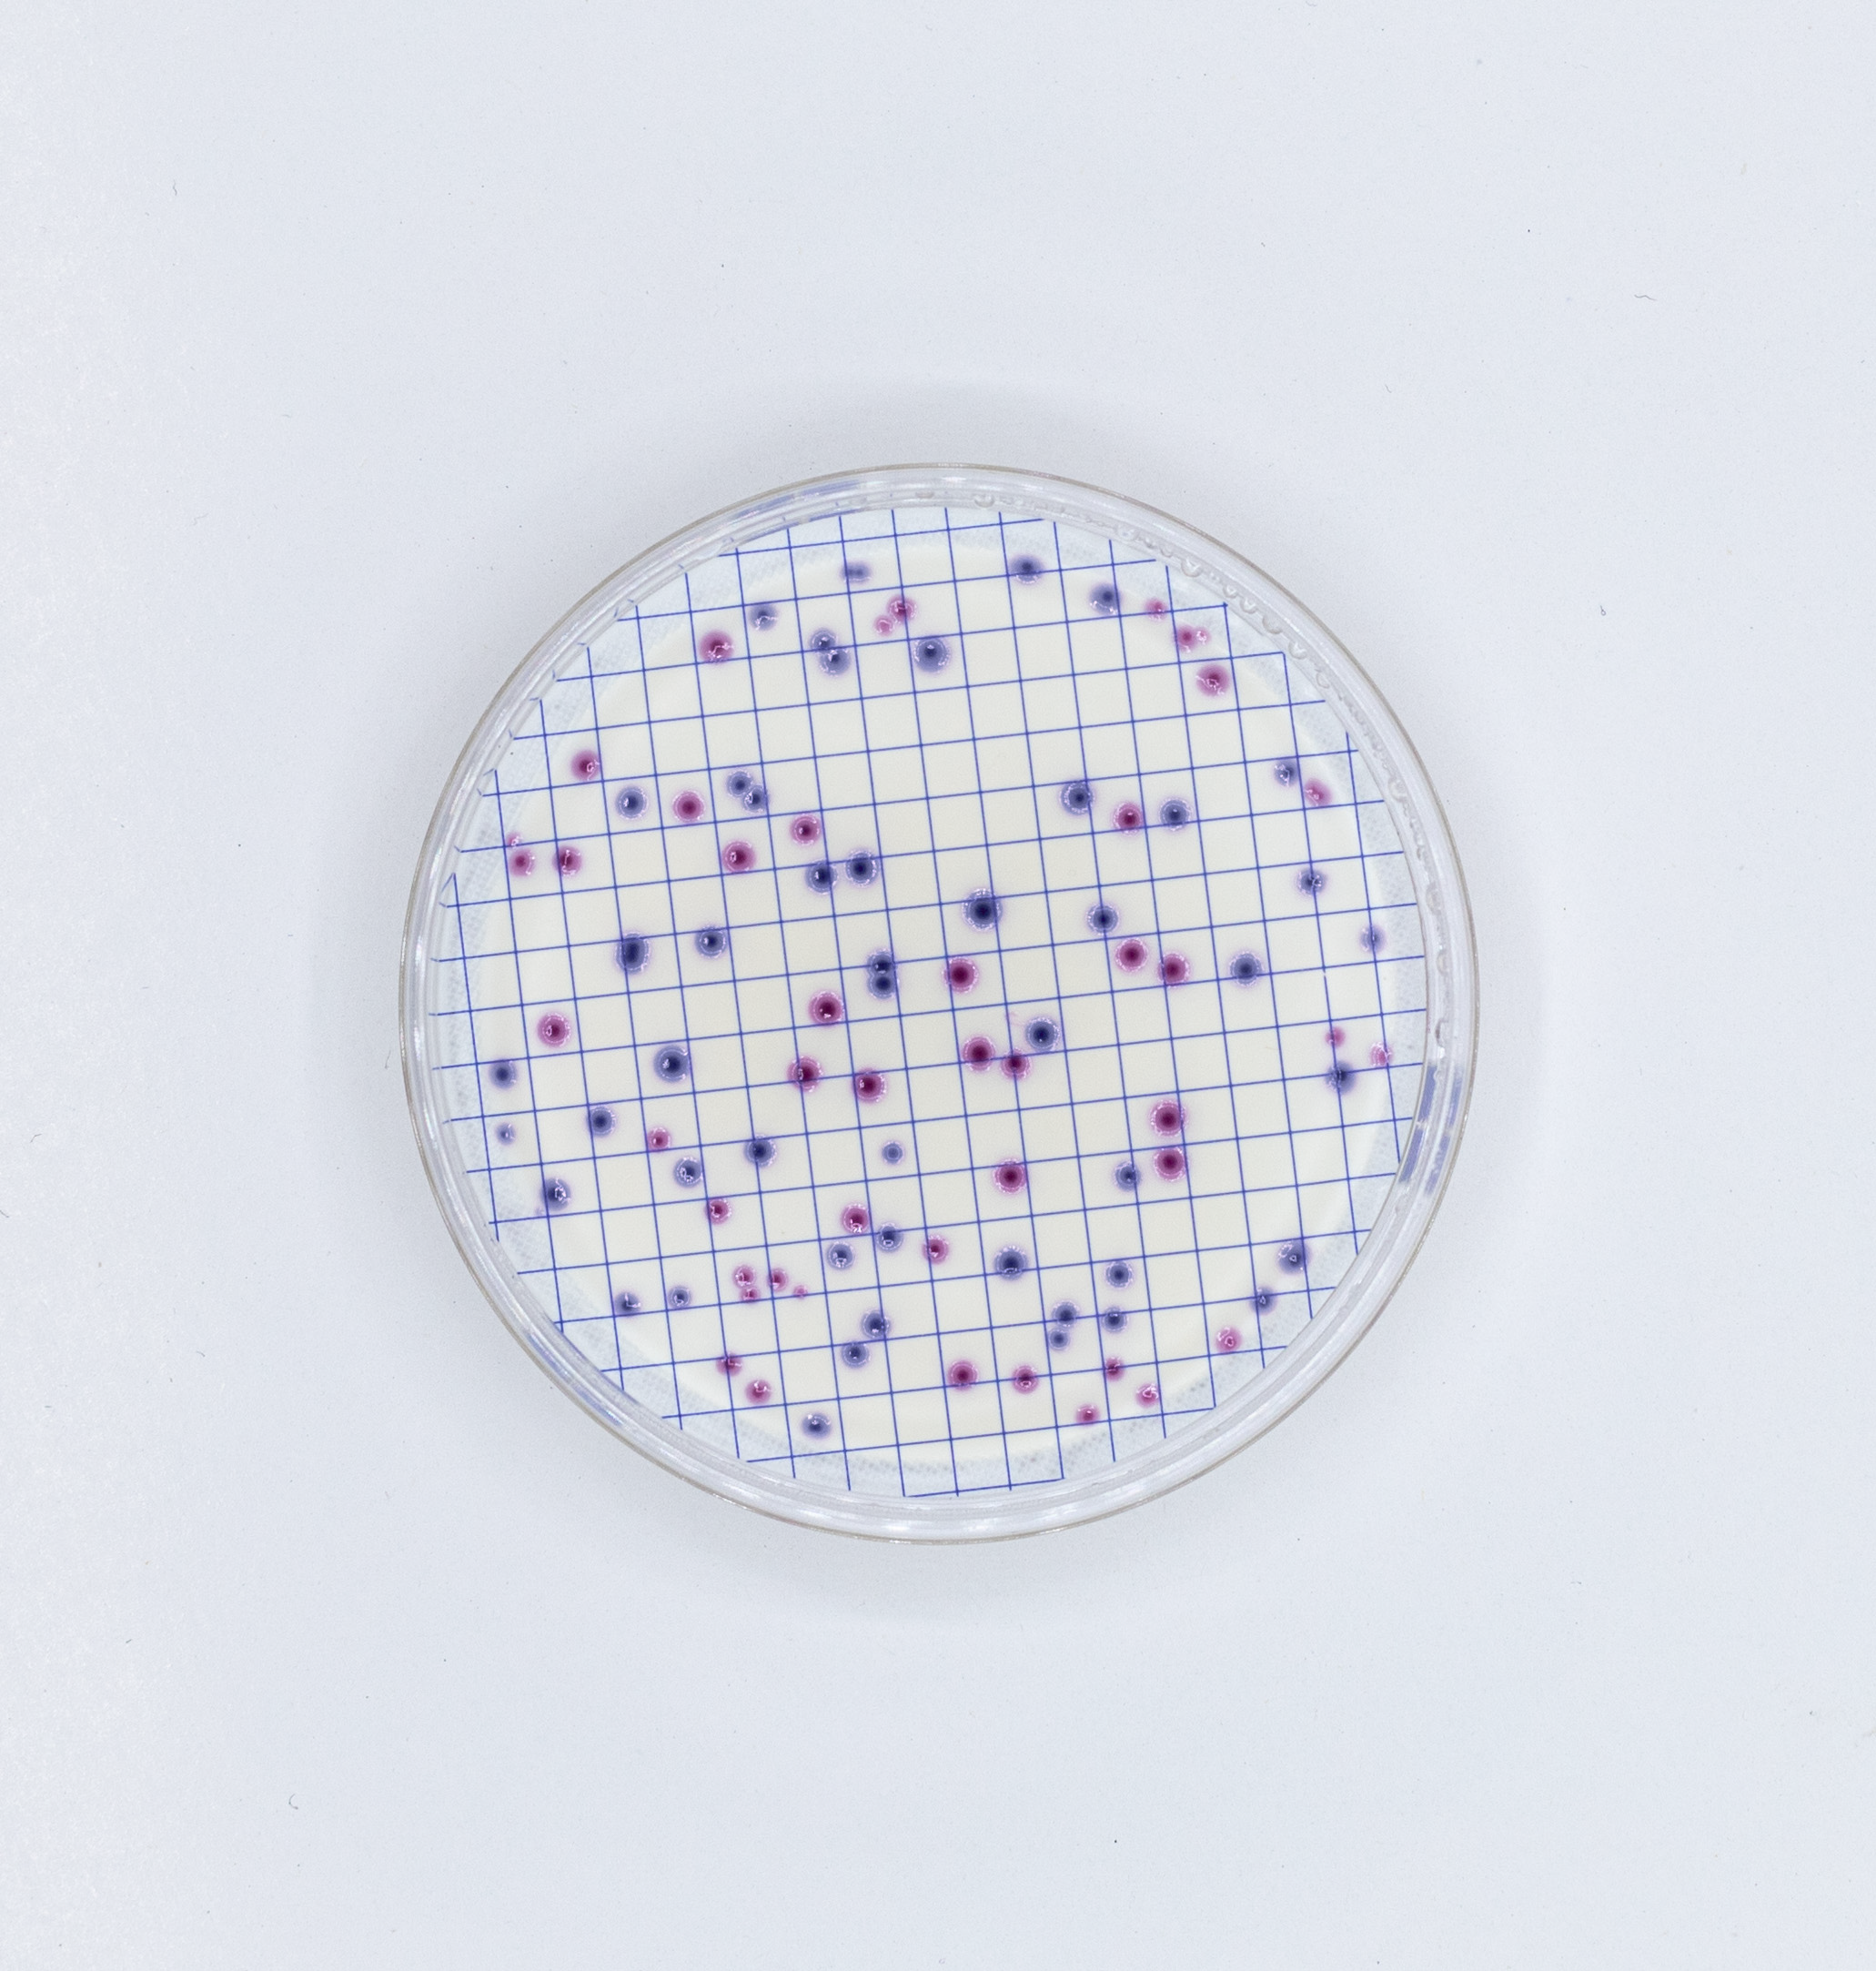
Ampoule Chromogenic broth E. coli/Coliforms

Chromogenic brothE. coli/Coliforms
Selective and differential medium for simultaneous detection ofE. coliand coliforms in water samples and beverages by membrane filtration.
Chromogenic brothE. coli/ coliformesampoule is a prepared medium, ready for use in membrane filtration analysis for the detection of total coliforms andE. coliin water samples. Recovery and enumeration ofEscherichia coliand coliforms are important indicators of environmental and food hygiene.
Principle of procedure
The interaction of the ingredients present in the medium, such as peptone, sorbitol and pyruvate, allows for rapid microbial growth, which includes infectious coliforms and also thermally damaged coliforms in a subletal manner. Tergitol-7 inhibits Gram positive and some Gram negative bacteria without affecting coliform bacteria. Sodium chloride maintains osmotic balance and phosphate salts act as a buffer system.
Yeast extract is a source of vitamins, particularly from group B. Casein enzyme digestide is a nitrogen-rich source. The presence of Salmon-GAL and X-glucuronide chromogenic substrates allows the identification and differentiation of coliforms andE. coliof the other bacterial groups by enzyme reactions.
The ß-D-galactosidase present in the coliforms scinds the substrate Salmon-GAL and generates red-salmon pigments, while the ß-D-glucuronidase, enzyme characteristic ofE. coli, split the X-glucuronide, giving blue to these colonies.E. colihas both enzymes and therefore produces dark blue to violet colonies.
Total coliforms are the sum of colonies ofE. colimore red/salmon colonies. In any case, it is recommended to verify the identity ofE. colithrough the detection of indol, since the culture medium has been enriched with tryptophan. This procedure involves covering the colony ofE. coli(dark blue-violet) with a drop of Kovacs Reagent for indol. If the reagent changes to red colouring at the top of the colony, the presence ofE. coli.